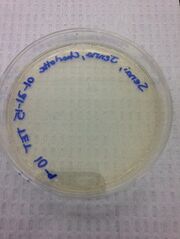
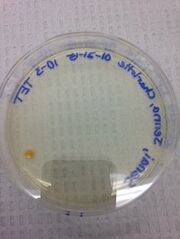
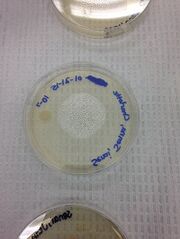
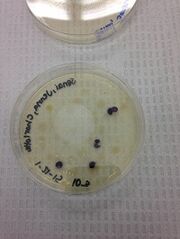

Uploads by Leo Roisman
From OpenWetWare
Jump to navigationJump to search
This special page shows all uploaded files.
| Date | Name | Thumbnail | Size | Description |
|---|---|---|---|---|
| 03:29, 24 March 2015 | Roismanzebrafishdata1.jpg (file) |  |
146 KB | |
| 03:29, 24 March 2015 | Zebrafishresults.pdf (file) | 42 KB | ||
| 03:28, 24 March 2015 | Zebrafishdata1.jpg (file) |  |
146 KB | |
| 19:52, 3 March 2015 | Roisman22.txt (file) | 2 KB | ||
| 19:52, 3 March 2015 | Roisman21.txt (file) | 2 KB | ||
| 23:12, 18 February 2015 | Roismantable2.jpg (file) |  |
140 KB | |
| 23:05, 18 February 2015 | Roismanfoodweb.jpg (file) |  |
51 KB | |
| 22:11, 18 February 2015 | Roismantable2,jpg.jpg (file) |  |
114 KB | |
| 02:16, 12 February 2015 | Roismanother.jpg (file) |  |
15 KB | |
| 02:15, 12 February 2015 | Roismanplanaria.jpg (file) |  |
18 KB | |
| 02:15, 12 February 2015 | Roismannematodes.jpg (file) |  |
15 KB | |
| 02:15, 12 February 2015 | Roismanannelida.jpg (file) |  |
17 KB | |
| 02:06, 12 February 2015 | Roismaninvertebratestable.jpg (file) | 113 KB | ||
| 04:33, 5 February 2015 | LeoRoismantable1.png (file) |  |
12 KB | |
| 04:32, 5 February 2015 | LeoRoismanhayinfusionaerial.JPG (file) |  |
28 KB | |
| 04:31, 5 February 2015 | LeoRoismanhayinfusion.JPG (file) |  |
31 KB | |
| 04:20, 5 February 2015 | LeoRoismanplantmatter.JPG (file) |  |
27 KB | |
| 04:20, 5 February 2015 | LeoRoismangel.JPG (file) |  |
24 KB | |
| 04:17, 5 February 2015 | LeoRoismanhayinfusionold.JPG (file) |  |
1.48 MB | |
| 04:05, 5 February 2015 | LeoRoismanchlamydomonas.jpg (file) |  |
9 KB | |
| 04:04, 5 February 2015 | LeoRoismanTable1.png (file) |  |
12 KB | |
| 04:04, 5 February 2015 | LeoRoismanparameciumaureli.jpg (file) |  |
5 KB | |
| 04:03, 5 February 2015 | Leoroismandidinium.jpg (file) |  |
7 KB | |
| 04:02, 5 February 2015 | LeoRoismancolpidium.jpg (file) |  |
24 KB | |
| 04:02, 5 February 2015 | LeoRoismanbursaria.jpg (file) |  |
8 KB | |
| 03:59, 5 February 2015 | LeoRoismanspirostomum.jpg (file) |  |
4 KB | |
| 03:58, 5 February 2015 | LeoRoismanyellowbacterialsample3.JPG (file) |  |
13 KB | |
| 03:58, 5 February 2015 | LeoRoismanyellowbacterialsample2.JPG (file) |  |
12 KB | |
| 03:57, 5 February 2015 | LeoRoismanyellowbacterialsample.JPG (file) |  |
10 KB | |
| 03:57, 5 February 2015 | LeoRoismanpurplebacterialsample2.JPG (file) |  |
11 KB | |
| 03:56, 5 February 2015 | LeoRoismanplatesaerial.JPG (file) |  |
27 KB | |
| 03:56, 5 February 2015 | LeoRoismanT9.JPG (file) | |
21 KB | |
| 03:55, 5 February 2015 | LeoRoismanT7.JPG (file) |  |
21 KB | |
| 03:55, 5 February 2015 | LeoRoismanT5.JPG (file) |  |
23 KB | |
| 03:54, 5 February 2015 | LeoRoismanT3.JPG (file) | |
22 KB | |
| 03:54, 5 February 2015 | LeoRoismanN9.JPG (file) |  |
25 KB | |
| 03:52, 5 February 2015 | LeoRoismanN7.JPG (file) | |
24 KB | |
| 03:52, 5 February 2015 | LeoRoismanN5.JPG (file) | |
24 KB | |
| 03:51, 5 February 2015 | LeoRoismanN3.JPG (file) |  |
21 KB | |
| 03:50, 5 February 2015 | LeoRoismanHayinfusionaerial.JPG (file) |  |
28 KB | |
| 03:49, 5 February 2015 | LeoRoismanHayInfusion.JPG (file) |  |
31 KB | |
| 03:42, 5 February 2015 | LeoRoismantransect.png (file) |  |
40 KB | |
| 02:40, 5 February 2015 | LeoRoisman yellowbacterialsample3.JPG (file) |  |
13 KB | |
| 02:40, 5 February 2015 | LeoRoisman purplebacterialsample2.JPG (file) |  |
11 KB | |
| 02:39, 5 February 2015 | LeoRoisman yellowbacterialsample.JPG (file) |  |
10 KB | |
| 02:39, 5 February 2015 | LeoRoismantable2.png (file) |  |
16 KB | |
| 00:11, 5 February 2015 | LeoRoisman T9.JPG (file) |  |
21 KB | |
| 00:11, 5 February 2015 | LeoRoisman T7.JPG (file) |  |
21 KB | |
| 00:11, 5 February 2015 | LeoRoisman T5.JPG (file) |  |
23 KB | |
| 00:10, 5 February 2015 | LeoRoisman T3.JPG (file) |  |
22 KB |